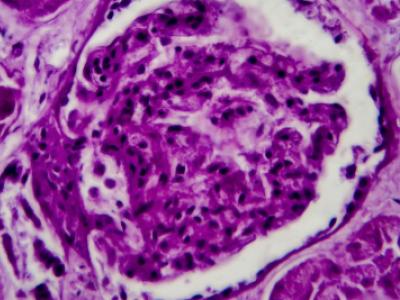

One-third of patients admitted with giant cell arteritis (GCA) were rehospitalized within 6 months, largely because of complications potentially related to corticosteroid therapy, researchers found in a retrospective cohort study.
Among the cohort of 1,206 patients hospitalized with GCA in the U.S., 6-month readmission rates stood at 34%, according to Radjiv Goulabchand, MD, of CHU Nîmes in France, and colleagues.